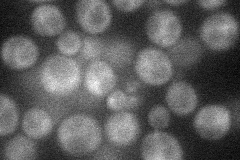
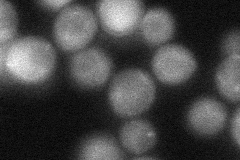
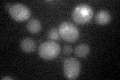

View description
Post-transcriptional gene regulator, flap-structured DNA-binding and RNA-binding protein; shows genetic interactions with Vti1p, a v-SNARE involved in cis-Golgi membrane traffic; stimulates Dna2p endonuclease activity; contains a SAM domain
Localization:
Intensity:
Fold change:
Significance:
-
C’ GFP library in SD

below threshold16.19 -
N' NOP1pr-GFP in SD
cytosol26.7644 -
N' TEF2pr-mCherry in SD

cytosol40.9322 -
N' NATIVEpr-GFP in SD

ambiguous19.0337 -
N' TEF2pr-VC and Cyto-VN in SD
cytosol41.3916 -
C’ GFP library in SD+DTT
cytosol17.131.05No -
C’ GFP library in SD+H2O2

cytosol13.90.85No -
C’ GFP library in Starvation Media

cytosol13.050.8No -
C’ GFP library on the background of Pup2-DaMP

below threshold -
C’ GFP library on the background of CCT mutant

below threshold17.8051.09905No
